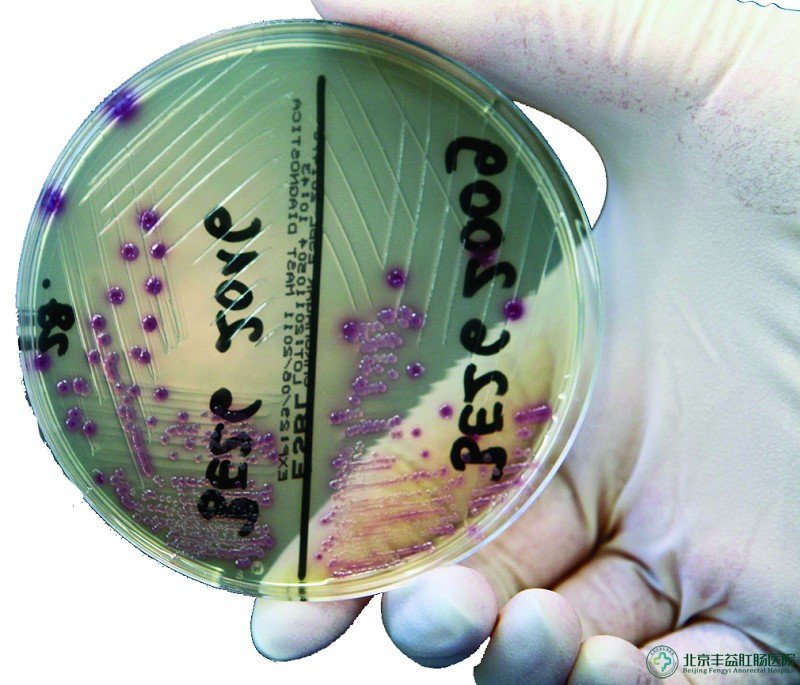

结肠炎怎么治疗好
北京丰益医院胃肠科专家团 作者:>丰益医院胃肠科主任 日期:2013-11-11 11:13
肠炎,是一种慢性、反复性、多发性的常见病,常表现为长期慢性、或反复发作的腹痛、腹泻及消化不良等症。
肠炎的发病率每年呈上升趋势,尤其是现在春末夏初时节,饮入不洁食物、饮料等都可能引发肠炎,导致腹泻不止,如不及时治疗就容易发展成为慢性肠炎。那么,慢性结肠炎怎么治疗好?
结肠炎怎么治疗好?——西医治标不治本
治疗肠炎,很多人选择吃一些抗生素类的西药,但是这些西药往往治标不治本,一旦停药就会出现反复发作的情形;此外,长期服用西药,会逐渐改变肠道的正常环境,降低肠道正常免疫力,对身体产生一定的毒。
慢性结肠炎怎么治疗好?——中医见效慢、有一定禁忌性
中医治疗肠炎,主要从其病因出发,以健脾补肾、益气除湿为治本之法,清热解毒、活血化瘀为治标之用,辨证施治,较忌长期应用大苦大寒之剂。
中医治疗肠炎,虽然具有治本优势,但是往往疗程久、见效慢,不能适应很多生活节奏较快的人的需求;同时,具有一定禁忌性,而且中药味苦,很多老人、孩子都拒服中药,从而不利于控制病情。
以上就是
丰益医院胃肠科专家的解释,如果您还有什么不了解的地方,可以点击咨询在线专家或者拨打在线专家电话
010-52227171